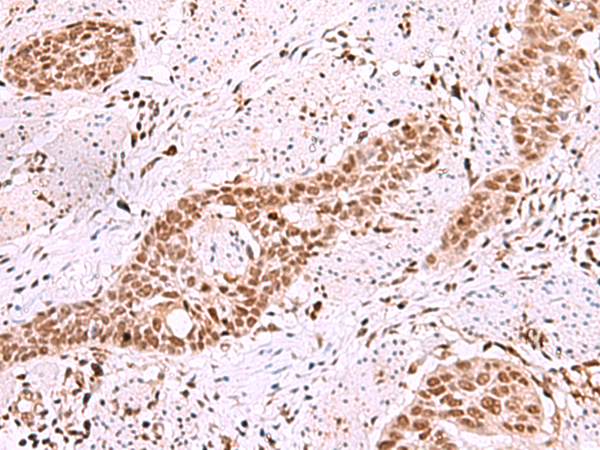

|
Background: |
Islet-2 (insulin gene enhancer protein ISL-2) is a 359 amino acid protein encoded by the human gene ISL2. Islet-2 is a nuclear protein that contains two N-terminal LIM domains, followed by a homeodomain and a serine/ glutamine/threonine-rich C-terminus. Islet-2 is a transcriptional factor that defines subclasses of motor neurons that segregate into columns in the spinal cord and select distinct axon pathways. Islet-1 and Islet-2 are initially expressed by all postmitotic spinal motor neurons prior to diversification of somatic and visceral neuronal fates. Somatic, but not visceral, motor neurons maintain Islet-2 expression at later embryonic stages. An early phase of Islet-2 expression by prospective visceral motor neurons of the sympathetic preganglionic motor column is critical for the emergence of complete visceral motor neuron character. Mutations that reduce or eliminate both Islet-1 and Islet-2 activity will result in pronounced defects in visceral motor neuron generation and eroded somatic motor neuron character. Transcriptional factor that defines subclasses of motoneurons that segregate into columns in the spinal cord and select distinct axon pathways. |
|
Applications: |
ELISA, IHC |
|
Name of antibody: |
ISL2 |
|
Immunogen: |
Synthetic peptide of human ISL2 |
|
Full name: |
ISL LIM homeobox 2 |
|
SwissProt: |
Q96A47 |
|
ELISA Recommended dilution: |
5000-10000 |
|
IHC positive control: |
Human esophagus cancer |
|
IHC Recommend dilution: |
40-200 |
購物車
幫助
021-54845833/15800441009
